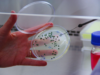
La levadura argentina que conquista al mundo del vino

Salta diseña una estrategia logística junto a Trenes Argentinos
La iniciativa busca integrar el transporte vial y ferroviario, sumar financiamiento privado y promover la creación de zonas francas y depósitos fiscales.
El ministro de...
Curso de “Rotulado de alimentos”
La actividad de capacitación es organizada por el INTA y la Fundación ArgenINTA, arancelada y requiere de inscripción previa.
En el predio del INTA Salta,...
Transforman residuos en un bioaceite con valor comercial
Investigadores desarrollaron un proceso que permite transformar la yerba mate usada en productos de valor industrial mediante pirólisis.
La yerba mate (Ilex paraguariensis) es un...
Vuelve a crecer la faena de hembras
De las 1.162.120 cabezas sacrificadas, el 48,2% corresponde a hembras, participación que vuelve a crecer respecto del 47,6% del mes previo.
Superior al millón de...
Fuerte suba para los terneros
Durante la última semana de octubre marcó un promedio de $3.523, lo que representa una suba nominal del 13%.
Tras las elecciones legislativas nacionales, el...
Se viene el remate “Mil Vientres 2025” en Cafayate
Este viernes 14 de noviembre, desde las 14 horas, se desarrollará en La Estancia de Cafayate el remate “Fin de Año NOA”, con transmisión...
Fendt amplía la oferta tecnológica en el agro argentino 🔊
La marca alemana presentó su portfolio para el país y anunció soporte técnico, agricultura digital integrada y un programa de garantía pensado para asegurar...
Jornada clave para el avance de la palticultura del NOA
El INTA Yuto reunirá a técnicos y productores del norte argentino en una jornada sobre producción de palta. El encuentro contará con especialistas del...
Senasa reunió al sector privado para definir prioridades
El organismo propuso una agenda de trabajo federal y participativa, en coordinación con el Consejo Federal Agropecuario.
Este martes, el Senasa convocó a representantes del...
Argentina se consagró en el Campeonato Mundial de Carnes
Un bife ancho a grano producido en Del Viso fue elegido el mejor del mundo y recibió además una mención especial por excelencia en...
Precios sostenidos para la carne
El estancamiento de la producción en Estados Unidos, Brasil y Europa debería respaldar los precios del ganado y la carne, trasladando los márgenes a...
Uruguay exporta más hacienda
La exportación de ganado en pie sumó casi 315 mil cabezas en lo que va del año, 11% más que en 2024.
En Uruguay la...
Brasil supera sus exportaciones de hacienda
Los embarques de ganado vivo crecen más de un 15% y pueden alcanzar 1,5 millones de animales en el año.
En Brasil las exportaciones de...
Jornada sobre microbioma del suelo hortícola en Orán
La jornada del INTA en Orán se enfocará en cromatografía, diversidad microbiana y estabilidad fisiológica de cultivos hortícolas.
El fortalecimiento de la salud del suelo...
Influenza aviar: acuerdo sanitario entre Senasa y Brasil
Se establece el reconocimiento recíproco de compartimentos libres y zonas indemnes para asegurar la continuidad del intercambio de productos aviares.
Con el objetivo de fortalecer...
El sebo vacuno suma valor y mercados
La planta Insuga incrementó por tercer año consecutivo sus envíos al exterior. Estados Unidos y Uruguay son los principales destinos del producto.
De enero a...
Actualizan los estándares de elaboración para chacinados
Con dos nuevas resoluciones, el Senasa incorpora productos y redefine ingredientes permitidos para adecuar la normativa a prácticas actuales de producción.
En el marco de...
San Juan: activan la segunda alerta fitosanitaria contra la Lobesia
Los productores deberán aplicar tratamientos autorizados hasta fines de noviembre para controlar el segundo vuelo de la plaga, según lo establecido por el Senasa.
El...
Inase extiende plazos para asegurar la pureza varietal
La decisión alcanza a cultivos como trigo, soja, maní y cebada cervecera y apunta a sostener información precisa en los sistemas de trazabilidad.
El Instituto...
Las finanzas, el agro y la minería sostienen la economía argentina
Son los sectores que crecieron en los últimos meses, en contraposición con la caída en la construcción, la industria y el turismo.
El periodista especializado...
Bajan los feedlots
A comienzos de noviembre registran una caída mensual del 4,4% y del 2,1% interanual, según el SENASA.
Continúa a la baja y por debajo de...
Se mueven los terneros
De enero a octubre de este año, los establecimientos de cría movilizaron un total de 9,5 millones de terneros y terneras con destino a...
Crece la liquidación de agrodólares
En lo que va del año el sector agroindustrial acumula ingresos por 29.564 millones de dólares que, comparado al 2024, tiene un incremento del...
Perspectiva agroclimática del ingeniero Eduardo Sierra
Conceptos vertidos por el ingeniero Eduardo Sierra, especialista en Agroclimatología, en el programa Claves del Campo -Radio Salta- del sábado 8 de noviembre de...
Presentaron oficialmente las Jornadas Bodegas de Salta
El evento se realizará el 3 y 4 de diciembre en el Centro de Convenciones Cafayate y reunirá a productores, bodegueros, técnicos y empresas...